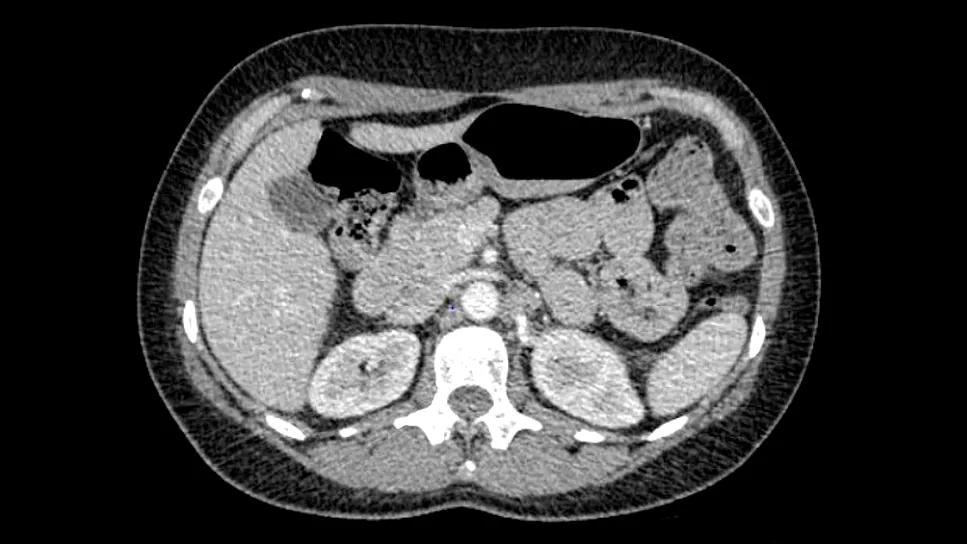

Highly personalized treatment shrinks tumors resistant to immunotherapy
Image content: This image is available to view online.
View image online (https://assets.clevelandclinic.org/transform/87a3f4a9-d396-45dd-90fa-754a72ebb467/tumor-infiltrating-lymphocyte-tlm-cases)
PET scan
A 42-year-old women with stage 4 conjunctival melanoma recently underwent the first-ever tumor-infiltrating lymphocyte (TIL) therapy at Cleveland Clinic Cancer Institute, with remarkable results.
Advertisement
Cleveland Clinic is a non-profit academic medical center. Advertising on our site helps support our mission. We do not endorse non-Cleveland Clinic products or services. Policy
Despite failing to respond to multiple types of immunotherapy, the tumor shrunk in size after TIL therapy and continues to do so.
TIL is personalized to the tumor and created directly from the patient. TIL cells already exist in the body and know how to identify and kill cancer cells, but there aren’t enough of them to do the job. TIL therapy involves expanding and activating the number of TIL cells and then reinfusing them back into the patient. The TILs have the potential to eradicate existing tumors as well as smaller cancer cells that may be circulating in the body.
In 2014, the patient was diagnosed with conjunctival melanoma, which has a high risk of recurrence. The initial treatment was excision of a mass in the eye’s connective tissue.
The disease returned in 2020, and the patient received the immunotherapy drugs ipilimumab and nivolumab for the subsequent two years. However, the disease progressed, and she experienced adverse events, including colitis that was severe enough to require four medications to get it under control.
She was hospitalized on several occasions, including an instance of neurological changes similar to Bell's palsy that were thought to be related to the immune therapy. In the meantime, the melanoma metastasized to lymph nodes in her abdomen.
Clinical trials in relapsed/refractory melanoma demonstrated that TIL therapy can achieve a durable response, even in many patients who have already received all standard lines of therapy. In 2024, TIL therapy was approved for patients with certain types of melanoma who had not responded to immunotherapy.
Advertisement
The patient’s clinical team presented the case to the Melanoma Tumor Board, which included members of the medical oncology, surgical oncology, radiology
and pathology teams. All members were in agreement that the patient was a strong fit for TIL therapy. The case was then presented to the Bone Marrow Transplant Committee to confirm that she met all clinical criteria to move forward with this novel treatment.
TIL therapy is challenging for patients with a high burden of melanoma or who are physically declining. However, the patient was young, had no other comorbidities and had an excellent performance status. Her tumor was also relatively small. All these factors made her an ideal candidate for TIL therapy.
TIL therapy involves several steps:
Advertisement
TIL therapy requires considerable coordination and effort. It can take several weeks or more to manufacture the TIL cells, and expediting this process is important to prevent further disease progression. To that end, the medical oncologist, surgeon, patient and the lab involved in manufacturing the TIL cells worked together to streamline the process so treatment could be initiated quickly.
The patient received her TIL infusion in August 2024 and responded very well. She had no serious side effects and was discharged home after two weeks. She felt well at discharge and was looking forward to returning to work shortly thereafter.
Since that time, two sets of scans showed the tumors are shrinking.

Image content: This image is available to view online.
View image online (https://assets.clevelandclinic.org/transform/eee6322f-3320-4369-ae0f-41c9be46e8fc/tumor-infiltrating-lymphocyte-til-inset)
Left to right: Pre-TIL, six weeks post TIL, 12 weeks post TIL
With TIL therapy, the response is expected to deepen over time as the TILs continue to seek out and kill cancer cells. The clinical team will continue to monitor the patient via regular imaging to ensure the disease stays under control.
“The patient did amazingly well,” says medical oncologist Lucy Kennedy, MD. ”She's been fighting this disease for years and suffered with severe toxicity before. It's been great to be able to offer TIL therapy and see her do so well.”
”T-cell therapies are an exciting new option,” says James Isaacs, MD. “These treatments offer great hope as we continue to work to offer new and innovative therapies.”
Although there are very effective immunotherapies with long-term durability for some types of melanoma, almost half of patients don’t respond. Others have substantial side effects. TIL therapy is becoming an important option for a subset of these patients.
Advertisement
Currently, TIL therapy is only offered at specialized centers. It does take several weeks or more to coordinate the treatment, so time is of the essence in considering this option. “Because it can be a long process, early communication is key,” says Dr. Isaacs. “If there is a patient with melanoma who is not responding to standard treatments, we would recommend being evaluated at a TIL center.”
Advertisement
Advertisement
Collaborative patient care, advanced imaging techniques support safer immunotherapy management
Cleveland Clinic Cancer Institute among select group of centers to administer highly personalized treatment
Researchers develop first-of-its-kind neoantigen atlas to better understand immunotherapy resistance
Patients receive specialized inpatient and outpatient care for cellular, gene and immune cell-engaging therapies
Clinicians highlight the need to educate patients about warning signs
Immune toxicity remains a diagnosis of exclusion, and multidisciplinary collaboration remains the cornerstone for early diagnosis and treatment.
Benefits of neoadjuvant immunotherapy reflect emerging standard of care
Phase 2 trials investigate sitagliptin and methimazole as adjuvant therapies